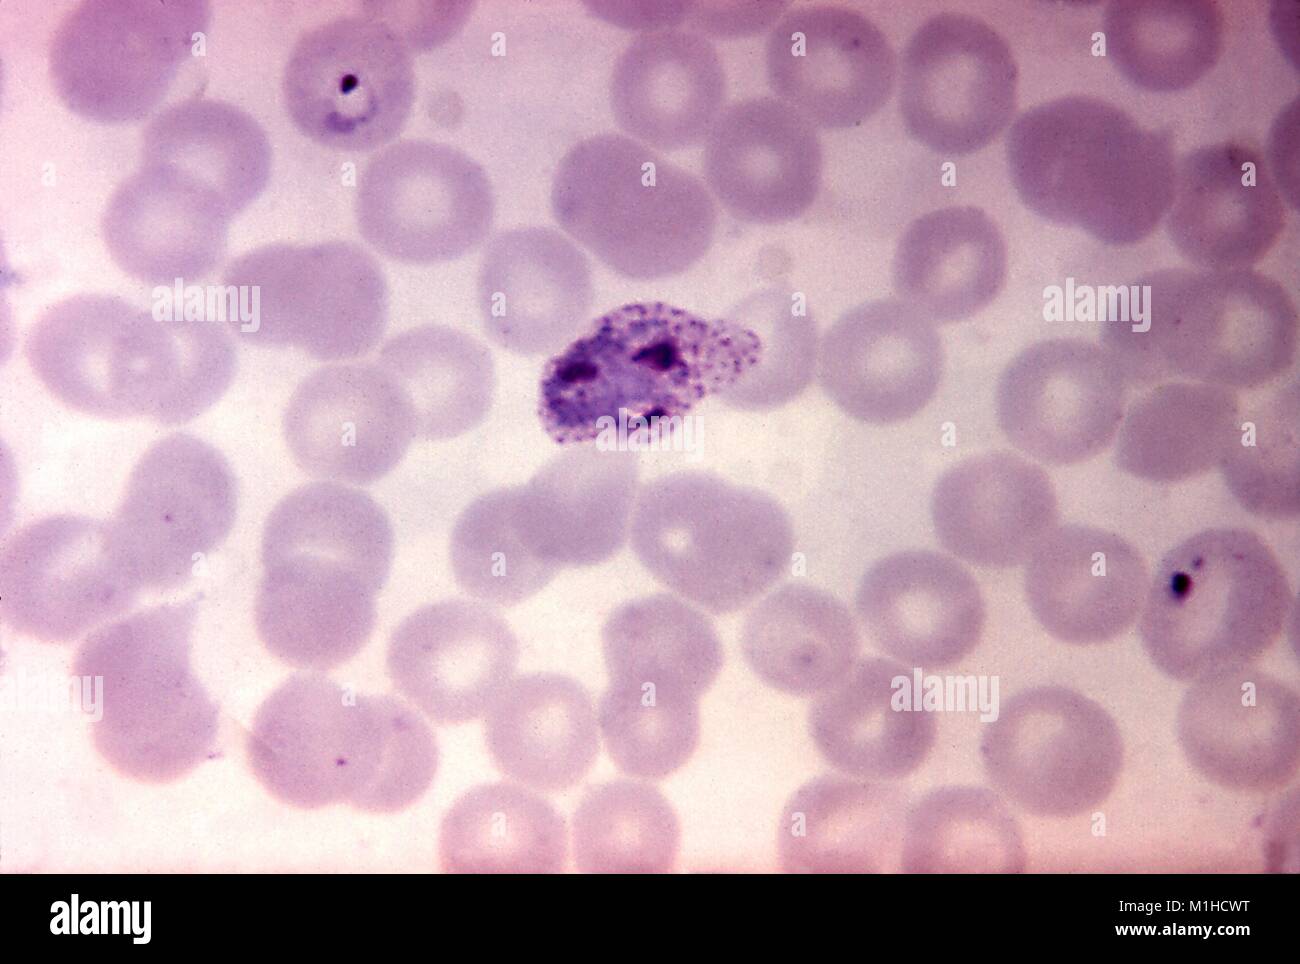
Photomicrograph der Malaria verursachen Parasiten Plasmodium vivax in ihrer Unreife schizont Phase, vergrößerte 1125 x, 1970. Mit freundlicher CDC. () Stockfoto

Photomicrograph der Malaria verursachen Parasiten Plasmodium vivax in ihrer Unreife schizont Phase, vergrößerte 1125 x, 1970. Mit freundlicher CDC. ()
RMID:Bild-ID:M1HCWT
Bilddetails
Bildanbieter:
Gado ImagesBild-ID:
M1HCWTDateigröße:
54,1 MB (1,1 MB Komprimierter Download)Freigaben (Releases):
Model - nein | Eigentum - neinBenötige ich eine Freigabe?Format:
5300 x 3565 px | 44,9 x 30,2 cm | 17,7 x 11,9 inches | 300dpiAufnahmedatum:
1. Januar 1970Ort:
United StatesFotograf:
Smith Collection/GadoWeitere Informationen:
Dieses Bild kann kleinere Mängel aufweisen, da es sich um ein historisches Bild oder ein Reportagebild handel